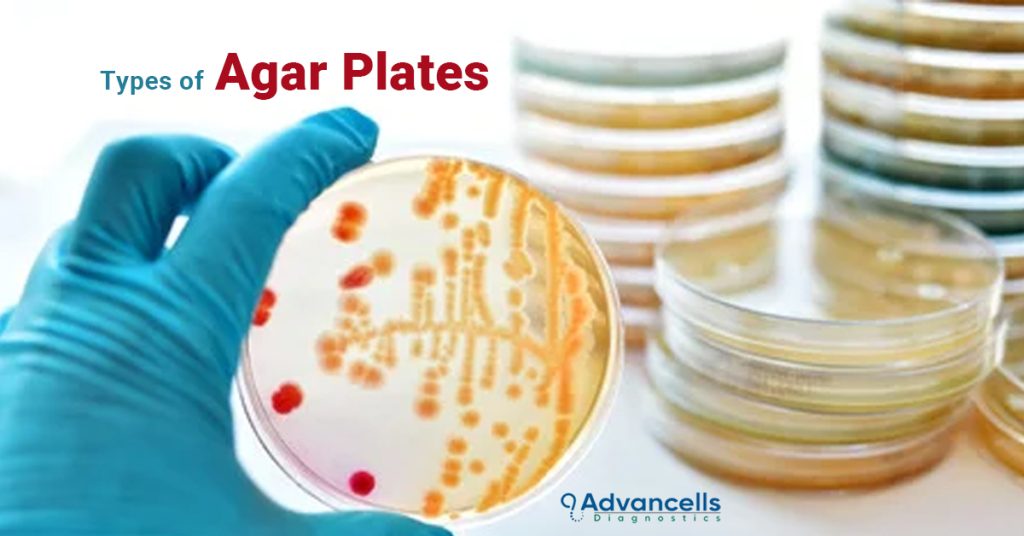
Types of Agar Plates

Product Portfolio
Covid-19 Solutions
Covid 19 has transformed some prevalent diagnostic industry assumptions and conceptions. As the saying goes, the rising tide raises all ships, we have witnessed that COVID 19 vaccines, kits and reagents were developed within a short period of time; considering the need of an hour. Like many of our industry partners, we have responded to this critical time of pandemic swiftly, scientifically and strongly by fulfilling the massive demands for COVID-19 detection products, such as Viral transport Medium, Viral Lysis Medium, Molecular transport Medium and many more.
Being committed to support the truly global efforts to fight the COVID-19 pandemic across multiple fronts; we have increased our manufacturing capacity in line with the rising demands during pandemic pressure. This robust response has seen our manufacturing and supply chain experts, technical experts and quality professional work in parallel to commercial production of COVID-19 solutions.
Viral Transport Medium Kit (VTM Kit)
Advancells Diagnostics Viral Transport Medium is a specially designed and formulated medium for the collection and transportation of viruses, especially COVID-19. It is designed to maintain the optimum viability and virulence in the sample. The viral transport medium is stable at room temperature.
It is made of Hanks’ Balanced Salt Solution (HBSS) and contains protective protein antibiotics to control microbial contamination and buffers to control the pH; which is per the guidelines prepared by WHO & CDC.
The kit is also composed of sterile, individually wrapped, and easy to collect specimen swabs for Nasal and Throat specimens. Both the swabs have breakpoints to make it easy for vial and sample transport after collection. The swabs can be collected in a single transport tube, provided along with the kit. The sterile absorbent pad will help to avoid any leakage.
Platelet Rich Plasma Kit (PRP Kit)
Advancells Diagnostics PRP kit is a point-of-care cellular platform to isolate and concentrate autologous growth factors, stem cells, and accessory cells that may help in optimizing the conditions for healing, making the use of autologous growth factor potential in the hospital and clinical setting.
This kit is by far the easiest way to recover about 80% of platelets and corresponding growth factors in the shortest period.
The Advancells Diagnostics PRP has been in thousands of procedures to date and counting today.
Agar Plates
Advancells Diagnostics ready-to-use Agar Plates are specifically designed for growth analysis, purification analysis, maintenance and/ or cultivation of non-fastidious /fastidious microorganisms. Ready-to-use agar plates provide all the necessary nutrients for optimum microbial growth and sustenance for routine research purposes.
Advancells Diagnostics Agar Plates are made as per the guidelines and specifications of European Pharmacopoeia and ISO regulations and are conveniently packed for safer storage and transportation.
BMC Kit
Advancells Diagnostics ready-to-use Agar Plates are specifically designed for growth analysis, purification analysis, maintenance and/ or cultivation of non-fastidious /fastidious microorganisms. Ready-to-use agar plates provide all the necessary nutrients for optimum microbial growth and sustenance for routine research purposes.
Advancells Diagnostics Agar Plates are made as per the guidelines and specifications of European Pharmacopoeia and ISO regulations and are conveniently packed for safer storage and transportation.
Synojel
Advancells Diagnostics ready-to-use Agar Plates are specifically designed for growth analysis, purification analysis, maintenance and/ or cultivation of non-fastidious /fastidious microorganisms. Ready-to-use agar plates provide all the necessary nutrients for optimum microbial growth and sustenance for routine research purposes.
Advancells Diagnostics Agar Plates are made as per the guidelines and specifications of European Pharmacopoeia and ISO regulations and are conveniently packed for safer storage and transportation.
About Us
Advancells Diagnostics is the growing diagnostic services provider across India. Our mission is to improve patient access to healthcare by making it more affordable, transparent, and trustworthy. Our company is dedicated, competent, and passionate about providing excellent diagnostic tools possible for hospitals and research. We strive to bring the best diagnostic services to our patients, colleagues, partners, and customers all across the world. Advancells Diagnostics provides a wide range of products, including COVID-19 diagnostic solutions as a consolidated approach to healthcare. Advancells Diagnostics is a primary manufacturer of Viral Transport Media (VTM) kits, a range of Agar Plates, Bone Marrow Concentrator (BMC) kits, Platelet-Rich Plasma(PRP) kits and Synojel. All our products are CE marked and accredited by the Indian Council of Medical Research (ICMR). We aim to bridge the gap by offering a wide variety of high-quality clinical diagnostics and point of care products to our specialized distributors.
Testimonials
Our customers love us! Read what they have to say about us.


OUR BLOG
Read our blogs to get a better understanding of the diagnostics and the healthcare sector